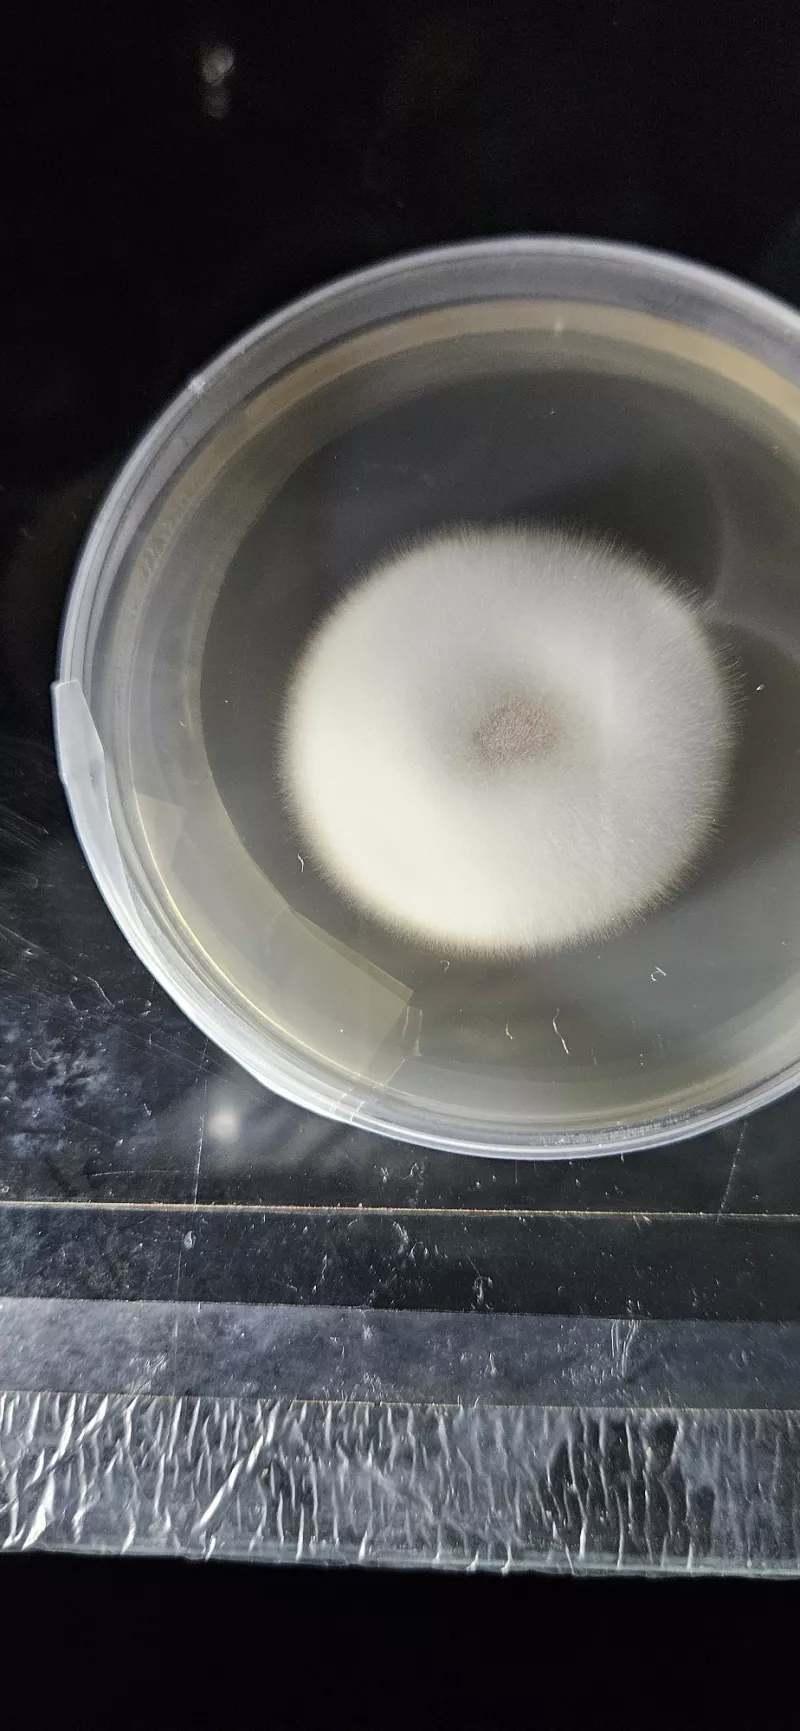
/forum/uploads/images/1708/mea2.webp
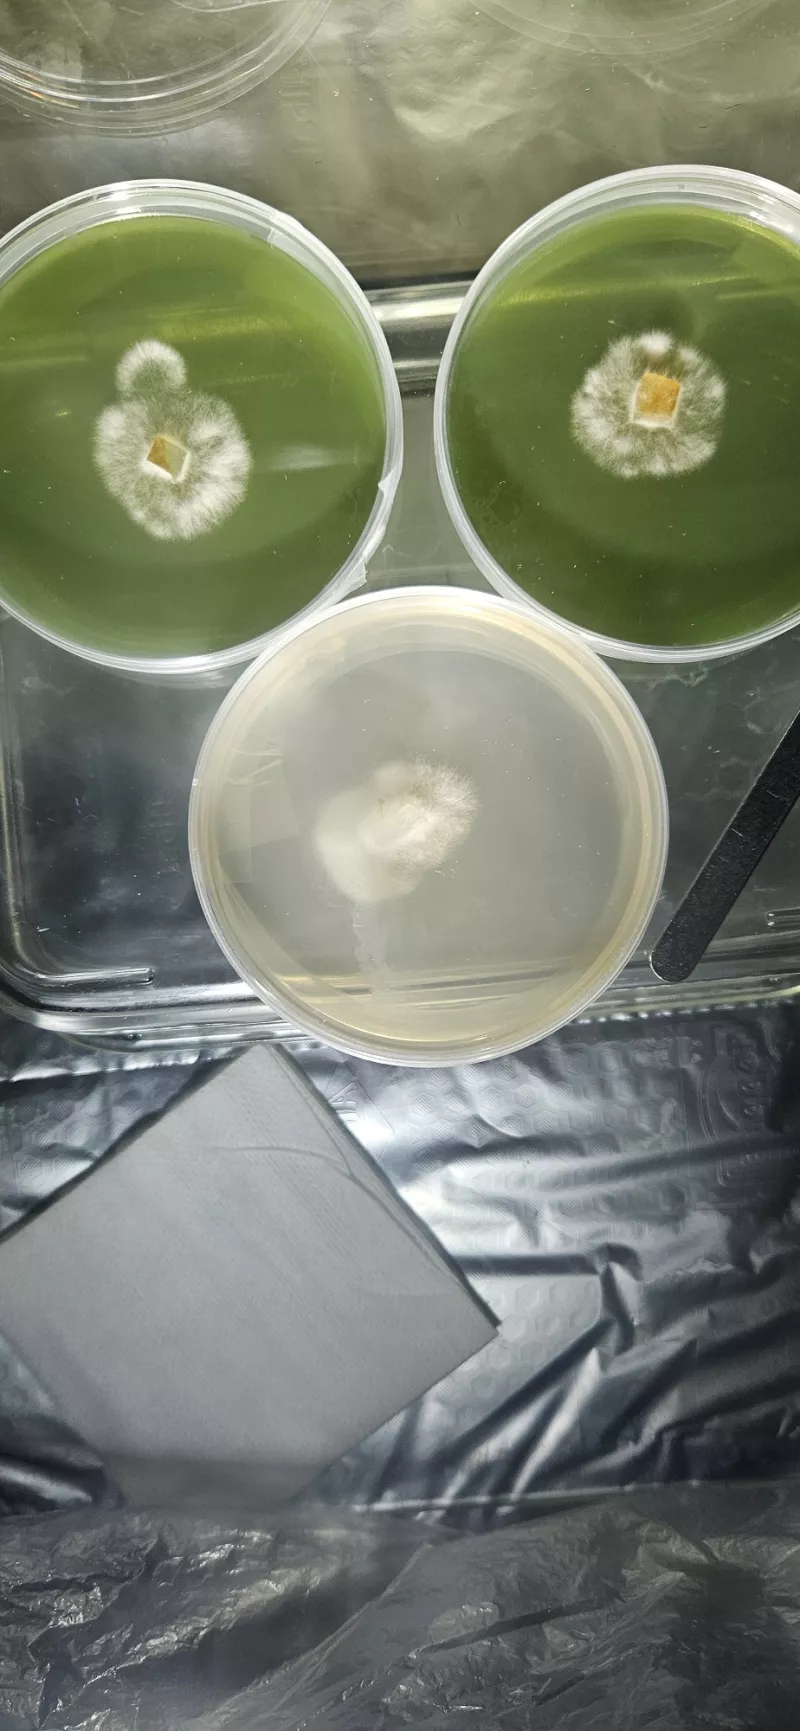
/forum/uploads/images/1708/2manures1mea-riso.webp

Hors ligne


Hors ligne

Hors ligne


Dernière modification par lulushroom (17 février 2024 à 23:01)
Hors ligne
Hors ligne

Hors ligne


Hors ligne

Anonyme 239 a écrit
Ils sont très beau tes champis, chapeau bien développé.
Tu les as pas fait poussé dans leur sac d'origine.
Merci pour les compliments psychopersonne.
Oui, je le dis dans mon message. J'ai une "martha tent", en fait c'est une mini serre de balcon avec brumisateur, ventilateur et sondes thermique et hygrométrique.
Ca permet de régler et d'optimiser les paramètres et bien sûr d'avoir plus d'espace dans la "chambre de culture".
Hors ligne

OscVaaa a écrit
J'attendais ces nouvelles depuis longtemps
Cool ! J'espère ne pas t'avoir déçu. :-)
Hors ligne

joel92 a écrit
OMG je ne savais pas que ces kits existaient, ça fait rêver
![]()
![]()
Je vais me renseigner.
ces photos sont magnifiques
Eh ! Eh !
Oui, c'est top !
Les renseignements ne devraient pas être trop durs à trouver. ;-)
Et merci pour les compliments !
Bonne culture à toi.
Dernière modification par lulushroom (21 février 2024 à 19:34)
Hors ligne

Hors ligne



Hors ligne

Dernière modification par SillyCone (22 février 2024 à 20:53)
Hors ligne

SillyCone a écrit
Pourquoi il est vert ?
Colorant alimentaire
Joli travail @lulushroom. Hâte de voir tes bulks de pan cyan. Par curiosité, le grain que tu utilises c'est un mélange pour oiseaux ?
Hors ligne

SillyCone a écrit
Jolie CL et jolies plaques d'agar !!!
Comment t'as fait pour faire un trou dans le verre ???
C'est une super idée de mettre le port d'injection à cet endroit, j'y avais jamais pensé !
CL Rose = contam.
Le mycélium des pans est très blanc, donc y a pas d'autres possibilités (et puis le rose, c'est d'office une contam, sauf dans le cas de la pleurota diamor, une pleurote toute rose).
Et c'est quoi ta recette de l'agar manure ? Pourquoi il est vert ?
En tout cas ton myc est très joli !
Merci SillyCone, oui j'adore l'aspect qu'a le mycélium.
Pour les trous dans le verre j'ai utilisé un foret diamant. Malgré le nom ce n'est pas bien cher. J'en ai eu 2 pour environ 12€.
La contamination je penche pour ça aussi. Je ne comptais de toute façon pas l'utiliser. Ça va finir dans le jardin ou dans l'évier. Je la garde (la CL) juste encore un peu en observation par curiosité pour voir l'évolution. J'espère que le 3ème et dernier bocal de LC ne va pas virer rose également...
La recette manure: j'ai utilisé 50 g de vieux crottin de cheval sec que j'ai fait bouillir 10 mn dans 500 ml d'eau.
Ensuite j'ai éteind le feu et j'ai laissé macérer pendant 12h avec un couvercle, puis filtré. Ensuite préparation classique d'agar avec cette eau "manurée". Si tu te retrouves avec moins de 500 ml tu rajoutes de l'eau et si tu as plus, tu réduis.
En effet, pour la couleur c'est du colorant alimentaire.
Ce n'est pas forcément toujours une bonne idée parce que ça pourrait empêcher de détecter précossement une potentielle contamination. Mais ça permet de bien voir le mycélium.
Là, je n'étais pas beaucoup chez moi mais j'y reviens aujourd'hui. J'ai hâte de voir l'évolution de tout ce petit monde tout blanc (et un peu rose
).
En parallèle, j'ai des petits pots PF tech de cubensis McKennaii qui se développent bien avec un beau mycélium rhisomorphique par endroit. C'est ma première PF tech (oui, je sais, on ne fait pas les choses dans cet ordre abituellement) mais c'est la première fois que je pars d'empreintes de spores. J'ai aussi in extrémis réussi à refaire de la culture liquide à partir d'une vieille seringue contenant mon premier clone de McKennaii.
J'ai fait pareil pour mon clone de Shiitake pris sur un champignon acheté sur un marché l'an dernier.
Donc j'ai 3 espèces sous forme de mycélium en cours.
Tiens ! J'ai une question pour toi. Comment nettoies-tu la toile plastique de ta Martha ?
A+ ! :)
Dernière modification par lulushroom (24 février 2024 à 16:37)
Hors ligne

anonyme 87 a écrit
SillyCone a écrit
Pourquoi il est vert ?
Colorant alimentaire
Joli travail @lulushroom. Hâte de voir tes bulks de pan cyan. Par curiosité, le grain que tu utilises c'est un mélange pour oiseaux ?
Oui c'est un mélange de graines d'oiseau.
Merci pour les encouragements !
La route est encore longue avant de pouvoir récolter mais c'est excitant de se relancer dans l'aventure.
Vive l'expérimentation ! :)
Dernière modification par lulushroom (24 février 2024 à 13:50)
Hors ligne

Hors ligne

En tout, j'en suis à environ 180g avec le premier kit.
41+70+53 sur les 3 premiers flushs et ensuite il a continué à produire des champi en moindre quantité mais c'est toujours ça de pris. Ca pousse encore à coup de 3 ou 4 champi à la fois maintenant. Je laisse pour voir jusqu'où il ira sans contamination.
Le deuxième kit a donné l'essentiel sur les 2 premiers flush:
50+67, en tout j'ai eu environ 130g. Il est contaminé à présent mais il continuait quand même à donner des champi. (je l'ai peut-être contaminé en voulant injecter de l'eau à cœur avec une seringue).
Je ne peux pas te répondre avec certitude mais c'est sûr que tu peux mieux optimiser les paramètres avec la Martha. En plus, une fois que c'est calé au niveau des réglages (Il faut un peu de matos en plus de la martha), tu peux laisser tourner sans t'en occuper.
J'ai quand même passé pas mal de temps à essayer d'ajuster les différents paramètres surtout au début.
En fait, il faut que le substrat soit bien humide, bien imbibé d'eau mais un air circulant pas trop humide. Plus de 90% d'hygrométrie quand même quand ils poussent. Pour que ça pin, je laisse un pourcentage au dessus de 95.
Je pense qu'il vaut mieux avoir un brumisateur à ultrason pour l'humidité et une arrivée d'air (ventilo d'ordi) à part.
Et ils aiment la chaleur.
Le fait d'avoir commencé avec les kits m'a permis de comprendre un peu mieux les différents besoins lors de la fructification.
Comme ça, si j'arrive à produire des pains non contaminés et les mettre en fructification, si ça ne donne rien, je saurai au moins que ça ne vient pas des conditions dans ma chambre de culture.
De ton côté, même si ça fait des flush moins gros, ton pain va peut-être continuer à donner des champi pendant longtemps.
De mon côté, j'ai dunké et mis au frigo pour le 3ème flush je crois (le frigo, pour le dunk, c'était à chaque fois) afin d'essayer de restimuler la croissance. Peut-être que ça a eu une influence positive.
Bonne culture à toi !
Hors ligne

Hors ligne

vhoenix a écrit
Ok ! car en gros je n'ai pas de Martha mais j'ai récupérer un frigo professionnelle de bar avec des portes coulissantes vitrées (je l'ai récupérer gratos car le système de froid ne fonctionne plus je pense que je le nettoyer et mettre un filtre a charbon sur les hélices d'entrée d'air pour l'apport d'air je pourrait modifié l'entrée d'air avec le système de filtre), je vais y mettre un système d'humidificateur Sonic a l'intérieur, je ferais un topic sur la transformation, mais sa me permettrais de faire jusqu'à 8 pains, divisée en 2 espèces sa pourrait bien rendre je pense et niveau esthétique sa peut rendre super bien et voir l'évolution sans filtres etc.
Chouette !
C'est un peu moins facile à modifier qu'une martha mais j'imagine que ça peut-être bien sympa.
Il faudrait que tu puisses régler l'intensité de la ventilation et prévoir une sortie d'air.
J'ai hâte de voir si tu arrives à transformer le tout en une jolie chambre de fructification efficace.
Bon bricolage ! :-)
Hors ligne







Dernière modification par lulushroom (18 mars 2024 à 23:51)
Hors ligne

Hors ligne

Hors ligne

Dernière modification par lulushroom (01 avril 2024 à 02:19)
Hors ligne

1 fan + 1 filter doesn't equal anything other than mold.
Why doesn't this "budget flowhood" work? Well, remember that laminar flow is required which is the product of resistance, velocity, and geometry; furthermore the filter is not designed to filter out microscopic particles with high efficiency.
A blower attached to a filter, or set of filters, would be more aptly called a "blowhood". The particle sampling data clearly illustrates how ineffective the standard hardware store filters are when it comes to filtration efficiency.
3 reasons why a boxfan/blowhoods fail to mimic actual clean benches:
1. The velocity produced by a box fan falls well short of the minimum required to produce laminar flow;
2. Hardware store filters are not the sort of filter designed for high efficiency particle filtration, even if they were, not all HEPA filters are designed for laminar flow applications;
3. The filter does not produce enough resistance and does not possess the correct internal geometry to align the airlflow into lamina.
As a result you're left with a turbulent flow machine that sucks in contaminant particles, (maybe the filter catches some of the larger debris like cat hair, etc) but ultimately blows microscopic particulate all over your work area.
Ensuite faut savoir qu'il renomme lui-même des noms de variétés par exemple le fameux "TTBVI" c'est juste BVI à la base. C'est d'ailleurs un sporetrader français très reconnus par les cultivateurs à l'international qui lui à envoyer une empreinte et qui à fais parvenir cette information après plusieurs confusions chez les cultivateurs de pans :
TTBVI are same as BVI, I sent one of my BVI print to Gordotek and as I explained him it was a guy named TamarindTreeBVI who found wild specimens and did the first wild prints Gordo called them TTBVI (so BVI = TTBVI even like any multi-spores some variations can occurs…)
Je suis d'accord que gordo est très généreux au niveau des spores, j'ai même reçu la variété Estero de sa part avant toute la hype sur la variété "TTBVI" mais personnellement je ne suivrais pas ses conseils en matière de myciculture
Dernière modification par anonyme 87 (01 avril 2024 à 16:26)
Hors ligne

anonyme 87 a écrit
Salut lulushrooms, désolé d'apprendre tes pertes.
Concernant la "hôte" de gordotek, parce que j'imagine que c'est à lui dont tu fais référence, des cultivateurs de longue dates sûr shr**mery ne le recommandent pas pour les raisons que je citerais ci-dessous. Personnellement je m'en tiendrais à rester sûr une still air box ou alors construire une vrais hôte à flux laminaire.1 fan + 1 filter doesn't equal anything other than mold.
Why doesn't this "budget flowhood" work? Well, remember that laminar flow is required which is the product of resistance, velocity, and geometry; furthermore the filter is not designed to filter out microscopic particles with high efficiency.
A blower attached to a filter, or set of filters, would be more aptly called a "blowhood". The particle sampling data clearly illustrates how ineffective the standard hardware store filters are when it comes to filtration efficiency.
3 reasons why a boxfan/blowhoods fail to mimic actual clean benches:
1. The velocity produced by a box fan falls well short of the minimum required to produce laminar flow;
2. Hardware store filters are not the sort of filter designed for high efficiency particle filtration, even if they were, not all HEPA filters are designed for laminar flow applications;
3. The filter does not produce enough resistance and does not possess the correct internal geometry to align the airlflow into lamina.
As a result you're left with a turbulent flow machine that sucks in contaminant particles, (maybe the filter catches some of the larger debris like cat hair, etc) but ultimately blows microscopic particulate all over your work area.Ensuite faut savoir qu'il renomme lui-même des noms de variétés par exemple le fameux "TTBVI" c'est juste BVI à la base. C'est d'ailleurs un sporetrader français très reconnus par les cultivateurs à l'international qui lui à envoyer une empreinte et qui à fais parvenir cette information après plusieurs confusions chez les cultivateurs de pans :
TTBVI are same as BVI, I sent one of my BVI print to Gordotek and as I explained him it was a guy named TamarindTreeBVI who found wild specimens and did the first wild prints Gordo called them TTBVI (so BVI = TTBVI even like any multi-spores some variations can occurs…)
Je suis d'accord que gordo est très généreux au niveau des spores, j'ai même reçu la variété Estero de sa part avant toute la hype sur la variété "TTBVI" mais personnellement je ne suivrais pas ses conseils en matière de myciculture
Bonsoir ♦aestheticspace♦019 et merci d'avoir pris le temps de m'écrire un message.
Merci aussi pour ta compassion. :-)
Je suis en train d'essayer à nouveau. Je viens d'inoculer des grains avec une CL de Pan Cyan issue de mon kit de chez z...
Pour la hôte à flux laminaire façon Gordo, la citation du blog de shr**mery ne semble pas faire référence au même système.
De toute façon, j'avais déjà acheté les éléments et j'ai donc bricolé la hôte façon Gordo. Je suis en train de faire des tests avec boîtes de pétris ouvertes, voir si ça fonctionne ou pas. Je serai ainsi fixé et je pourrai alors te dire si tu as raison ou non.
Avant de tirer des conclusions, il faut que je fasse plusieurs tests car même avec les bons éléments (notamment filtre HEPA) il faut trouver le bon débit d'air.
Mais rassure toi, je n'ai pas jeté ma "still air box". ;-)
Oui, j'avais vu que BVI et TTBVI était la même souche.
En plus de toutes les infos que je trouve avec Gordo, c'était l'occasion pour moi d'acquérir des empreintes de spores de qualité à un pris dérisoire. D'ailleurs, en même temps, il m'a aussi envoyé des spores de nathalensis.
D'ailleurs, sur le chat', beaucoup d'abonnés ont l'air d'avoir du succès en appliquant ses conseils et techniques, y compris pour la hôte.
Je respecte ton avis mais je vais bien me rendre compte par moi même si ça peut fonctionner ou pas.
Je te tiendrez au courant de mes expériences.
A bientôt ! :-)
Dernière modification par lulushroom (04 mai 2024 à 23:37)
Hors ligne

Dernière modification par lulushroom (12 mai 2024 à 21:36)
Hors ligne










Dernière modification par lulushroom (22 juin 2024 à 19:02)
Hors ligne

Dernière modification par SillyCone (23 juin 2024 à 23:12)
Hors ligne

Hors ligne